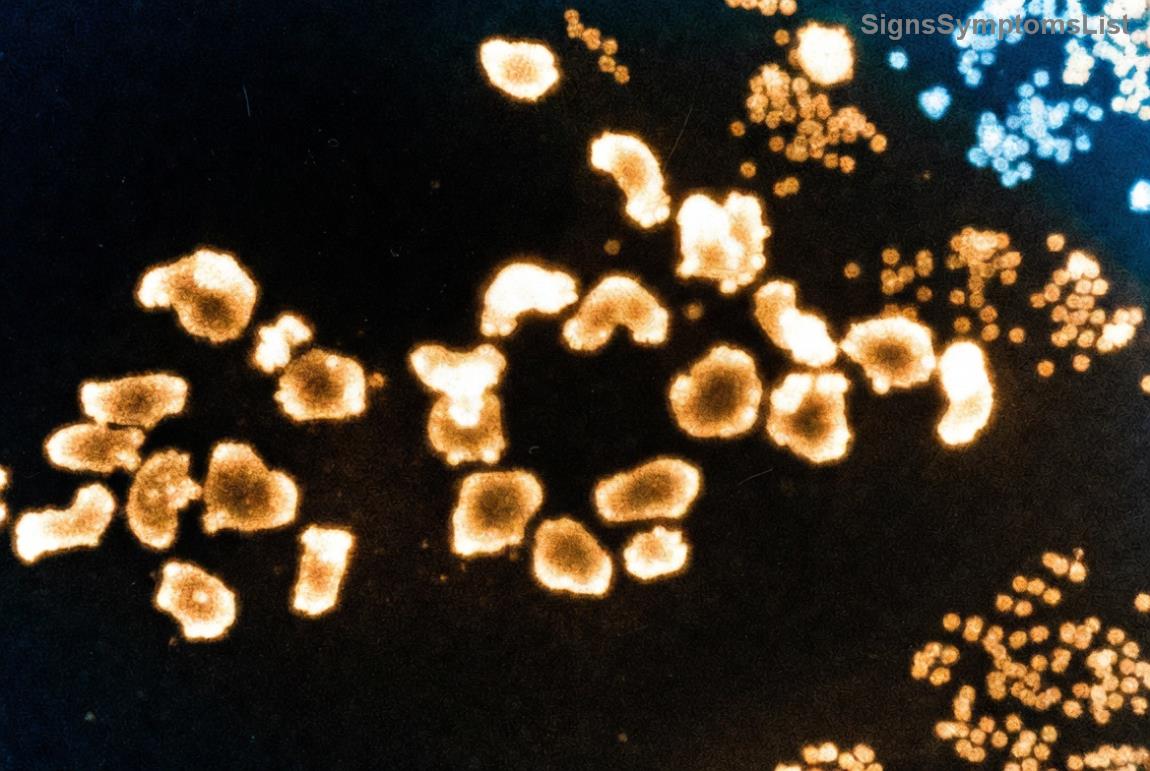
Colorful array of safe, nutrient-dense foods like fruits, vegetables, and proteins arranged appealingly, inspiring healthy eating for cancer patients

Living with leukemia can feel overwhelming, but taking control of your nutrition is a powerful step toward better health. As an immunocompromised patient, your body needs extra care to fight infections and support treatment. This leukemia diet guide focuses on safe eating practices that prioritize safety, nutrition, and enjoyment. We'll explore practical strategies to nourish your body without unnecessary risks, helping you feel empowered and optimistic on your journey.

Understanding the Role of Diet in Leukemia Management
For those battling leukemia, a well-planned diet isn't just about calories—it's about fueling your immune system and aiding recovery. Chemotherapy, radiation, and medications can weaken your defenses, making food safety paramount. According to recent guidelines from oncology experts, a nutrient-dense diet can help maintain energy levels, reduce side effects like nausea, and promote overall well-being.
🛡️ Key Principle: Focus on foods that are easy to digest, rich in vitamins, and low in contamination risks. This approach not only supports your body's fight against cancer but also brings a sense of normalcy and joy to daily meals.
Core Safe Eating Practices for Immunocompromised Patients
Safety first! Immunocompromised patients are more vulnerable to foodborne illnesses, so adopting these safe eating practices is crucial. Start small—pick one or two to implement today—and build from there for lasting impact.
- ✨ Wash Produce Thoroughly: Rinse fruits and vegetables under running water, even if pre-washed. For extra caution, use a vinegar solution (1 part vinegar to 3 parts water) to kill bacteria. This simple step protects against pathogens like E. coli.
- 🧼 Cook Foods to Safe Temperatures: Use a food thermometer to ensure meats reach 165°F (74°C) internally. Avoid undercooked eggs, poultry, or seafood—raw or rare preparations are off-limits in this leukemia diet guide.
- 🚫 Avoid High-Risk Foods: Steer clear of unpasteurized dairy, raw sprouts, deli meats (unless heated to steaming), and unwashed herbs. These can harbor Listeria or Salmonella, which pose serious threats to weakened immune systems.
- 🥛 Opt for Pasteurized and Processed Safely: Choose pasteurized juices, cheeses, and milks. For fresh salads, prepare them at home with clean tools to minimize cross-contamination.
- 🛒 Smart Shopping Habits: Select items with intact packaging and check expiration dates. Shop during less crowded times to reduce exposure to germs.
Implementing these practices can significantly lower infection risks, giving you peace of mind and more energy for what matters most—your recovery.
Nutrient-Rich Foods to Include in Your Leukemia Diet
A balanced leukemia diet emphasizes whole foods that provide essential vitamins, minerals, and antioxidants. Recent studies highlight how these nutrients can help combat fatigue and support blood cell production. Aim for variety to keep meals exciting and your palate satisfied.
| Nutrient Category |
Recommended Foods |
Benefits for Immunocompromised Patients |
| Proteins |
Cooked lean meats, eggs, tofu, Greek yogurt (pasteurized), nuts (if no allergies) |
Builds and repairs tissues; supports immune function during treatment |
| Vitamins A & C |
Carrots, sweet potatoes, bell peppers, citrus fruits (peeled), berries |
Boosts white blood cell production; enhances antioxidant defenses |
| Iron & Folate |
Leafy greens (cooked spinach), fortified cereals, lentils, lean beef |
Aids red blood cell formation; combats anemia common in leukemia |
| Healthy Fats |
Avocados, olive oil, fatty fish like salmon (well-cooked) |
Provides energy; reduces inflammation |
| Hydration Boosters |
Water, herbal teas, clear broths, electrolyte drinks (low-sugar) |
Prevents dehydration from treatments; flushes toxins |
Pro Tip: Start your day with a smoothie blending spinach, banana, and pasteurized yogurt—it's gentle on the stomach and packed with goodness. 😊 These choices not only nourish but also remind you of your strength in facing leukemia.

Managing Common Side Effects with Diet
Treatments for leukemia often bring challenges like mouth sores, nausea, or taste changes. Tailor your leukemia diet guide to ease these—small, frequent meals can make a big difference.
- 🌟 For Nausea: Ginger tea or bland foods like rice, bananas, and toast (the BRAT diet). Avoid greasy or spicy items to keep symptoms at bay.
- 😌 For Mouth Sores: Soft, cool options such as smoothies, mashed potatoes, or scrambled eggs. Rinse with saltwater after meals for relief.
- 🍲 For Taste Alterations: Experiment with herbs like basil or lemon zest instead of salt. Metallic tastes? Pair proteins with sweet fruits to balance flavors.
- ⚠️ Weight Maintenance: If appetite wanes, try high-calorie shakes with peanut butter and oats. Consult a dietitian for personalized tweaks.
Remember, listening to your body is key. These adjustments can turn mealtime from a chore into a comforting ritual, fostering a positive mindset.
Sample Meal Plan: A Day in Your Safe Leukemia Diet
To make this actionable, here's a simple, safe daily plan inspired by the latest oncology nutrition recommendations. Adjust portions based on your needs and consult your healthcare team.
Breakfast
Oatmeal topped with sliced bananas and a sprinkle of cinnamon. Pair with pasteurized yogurt for protein. (Hydrate with herbal tea.)
Mid-Morning Snack
A handful of cooked carrots or apple slices (peeled and washed). Keeps energy steady without overwhelming your system.
Lunch
Grilled chicken breast with steamed broccoli and quinoa. Drizzle with olive oil for healthy fats. Simple, satisfying, and immune-supportive.
Afternoon Snack
Smoothie: Blend spinach, berries, and almond milk (pasteurized). Refreshing and nutrient-packed! 😊
Dinner
Baked salmon with sweet potato mash and cooked green beans. Omega-3s from fish help reduce inflammation.
Evening Snack
Cottage cheese (low-fat, pasteurized) with a few crackers. Winds down the day gently.
This plan totals around 1,800-2,200 calories, emphasizing balance. Track how you feel and refine it—your journey deserves flexibility and care.
Additional Tips for Long-Term Success
Beyond the plate, integrate these habits:
- 👩⚕️ Work with Professionals: A registered dietitian specializing in oncology can customize your leukemia diet guide. For evidence-based advice, explore resources from trusted organizations like the American Cancer Society.
- 📝 Keep a Food Journal: Note what energizes you versus what doesn't. This builds awareness and prevents setbacks.
- 🌈 Add Joy to Eating: Involve family in meal prep or try new recipes. Positive emotions enhance digestion and overall health.
- 💧 Stay Hydrated: Aim for 8-10 glasses of water daily. Infuse with cucumber or mint for flavor without risks.
As you navigate safe eating practices, celebrate small wins—like enjoying a favorite food safely. You're not alone; this guide is your ally in reclaiming vitality.
Final Thoughts: Empower Your Recovery
Embracing a thoughtful leukemia diet guide transforms challenges into opportunities for strength. By prioritizing safe eating practices for immunocompromised patients, you're investing in a brighter, healthier future. Stay consistent, seek support, and let nutrition be your source of hope. You've got this—keep shining! 🌟
For more personalized guidance, always consult your doctor or a nutrition expert. Your path to wellness is unique and worth every mindful bite.